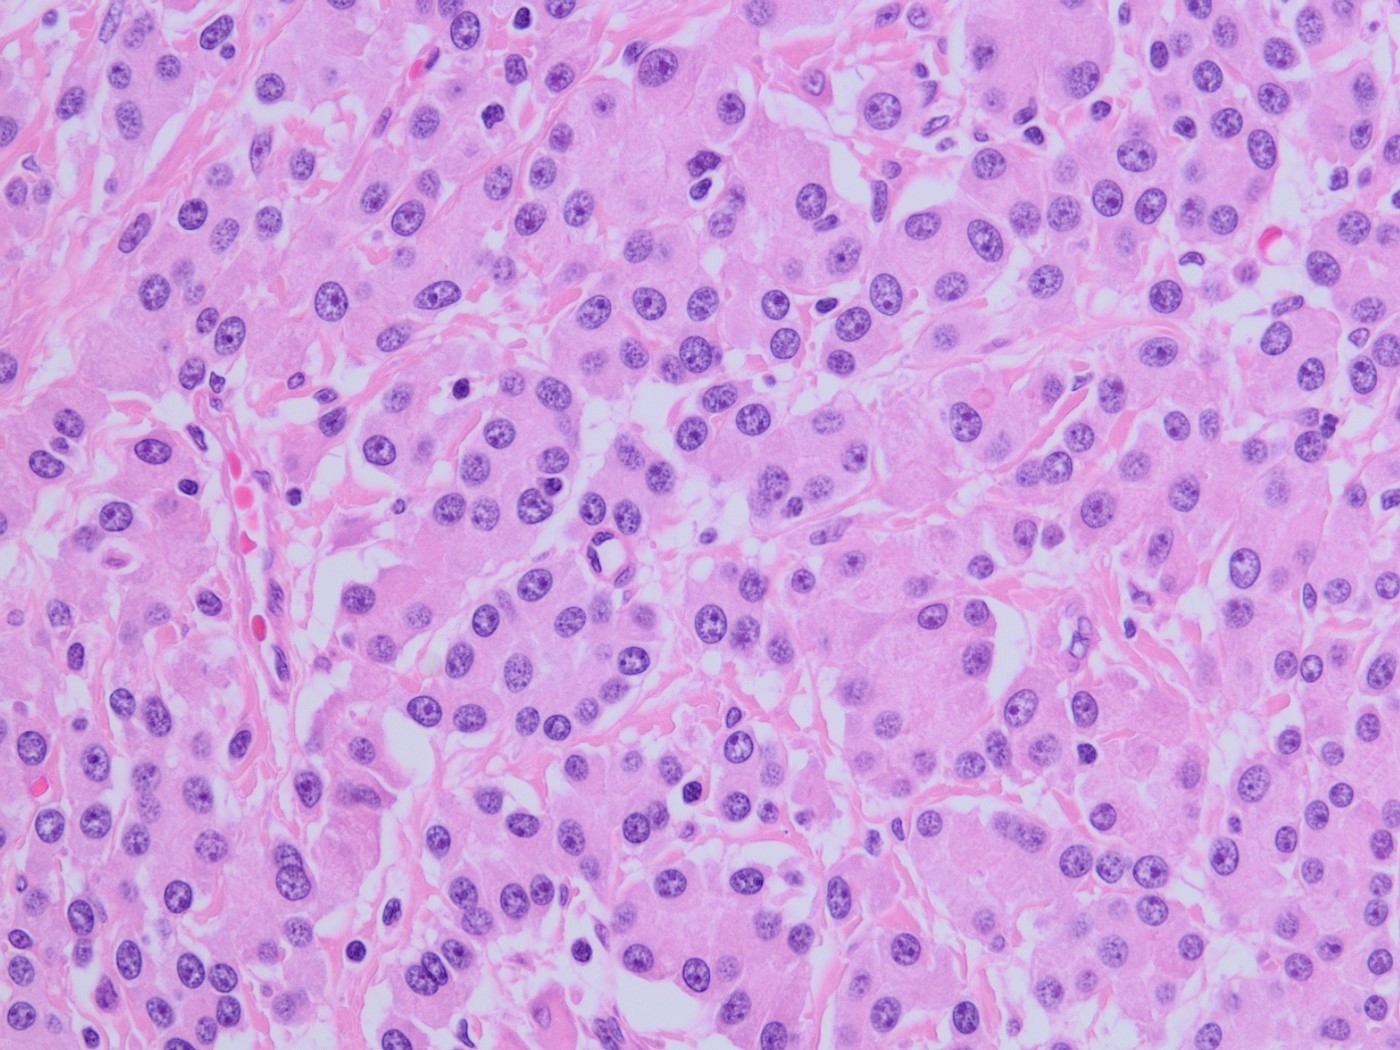
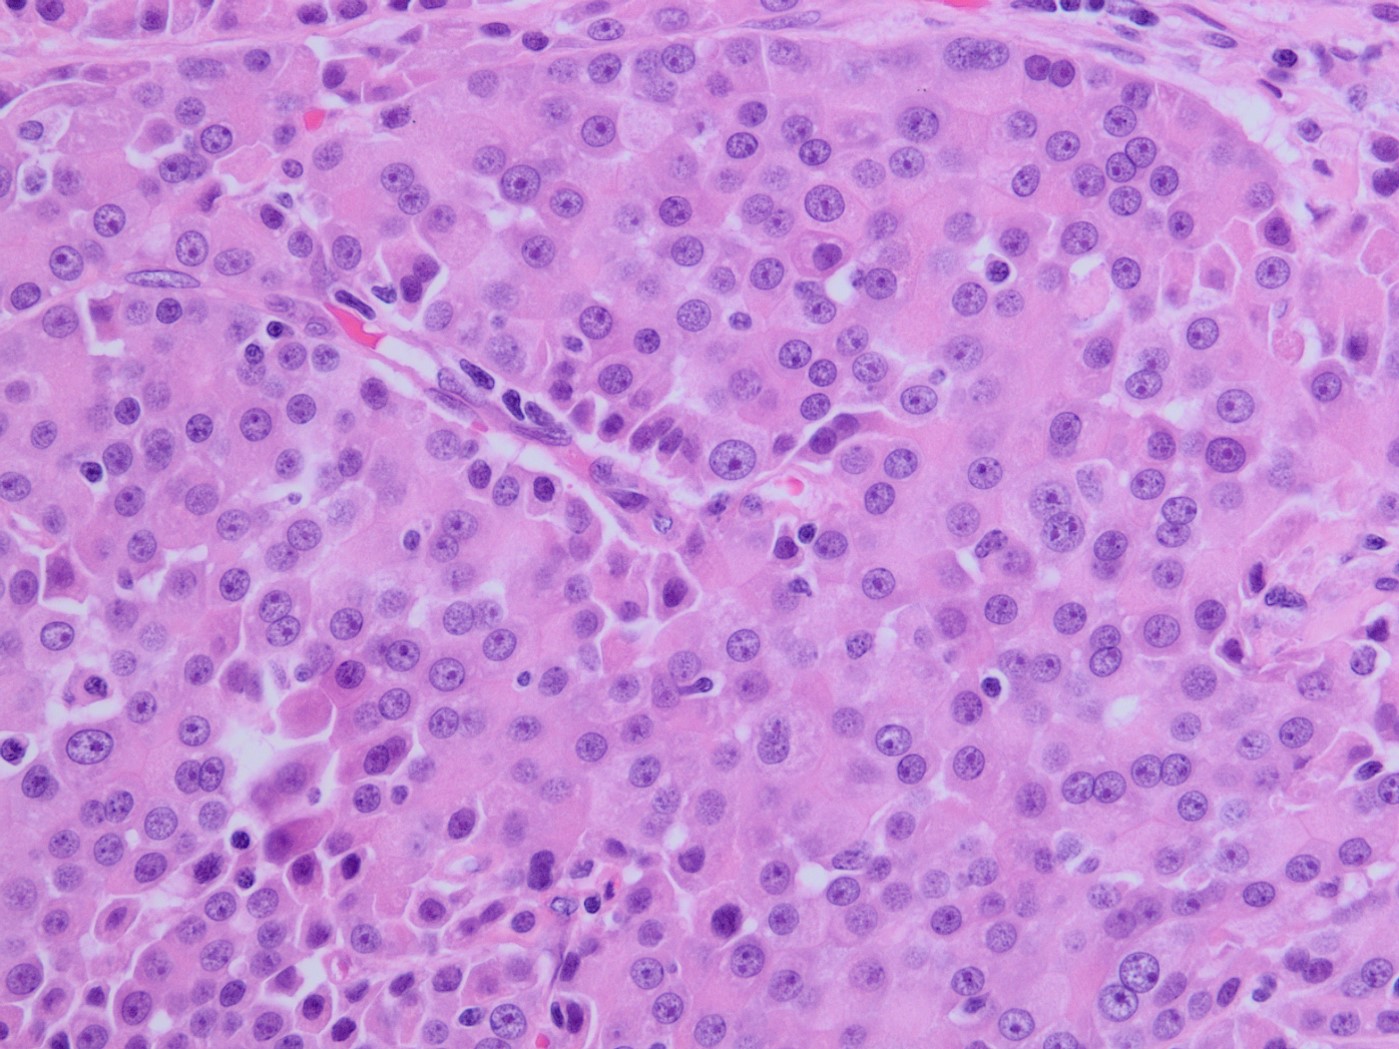

Case History
A 75-year-old woman with suspected pancreatic NET undergoes a Whipple. The morphology of the tumor is seen in Fig A-D. A synaptophysin is performed (Fig E). What additional IHC profile can be expected in this tumor?
- Nuclear beta-catenin (+), CK (-)
- Chromogranin (+), Ki67 (>2% per HPF)
- Trypsin (+), BCL10 (+)
- Trypsin (+), Nuclear beta-catenin (+ in squamoid nests)

Answer:
“C.” Trypsin (+), BCL10 (+)

Brief explanation of the answer:
The tumor is solid and cellular with the individual cells displaying abundant granular cytoplasm and round monotonous nuclei with prominent nucleoli, configured in a vague acinar formation. These features are consistent with an acinar cell carcinoma, therefore positive staining for trypsin and BCL10 are expected (figures).
The main differential diagnosis in this case is a well differentiated neuroendocrine tumor. However, a stain for synaptophysin stain is negative, with an islet serving as an internal control. This finding rules out a neuroendocrine tumor, therefore chromogranin would also likely be negative. Acinar cell carcinoma can sometimes have weak staining for neuroendocrine markers, however the KI67 index should be high in acinar cell carcinoma. Pancreatoblastoma is also an important differential diagnosis for acinar cell carcinoma. The background of pancreatoblastoma is often that of an acinar pattern with corresponding trypsin positivity. However, pancreatoblastoma will contain squamoid nests that show nuclear staining for beta-catenin. Solid pseudopapillary neoplasm (SPN) should also be considered as a differential, as it is a solid and cellular neoplasm with bland cytology. However, acinar cell carcinoma lacks the distinctive small capillaries and pseudo papillae formation seen in SPN. SPN will also have characteristic nuclear beta catenin staining.
Case contributed by Jessica Tracht, M.D., Assistant Professor, Anatomic Pathology, UAB Department of Pathology
